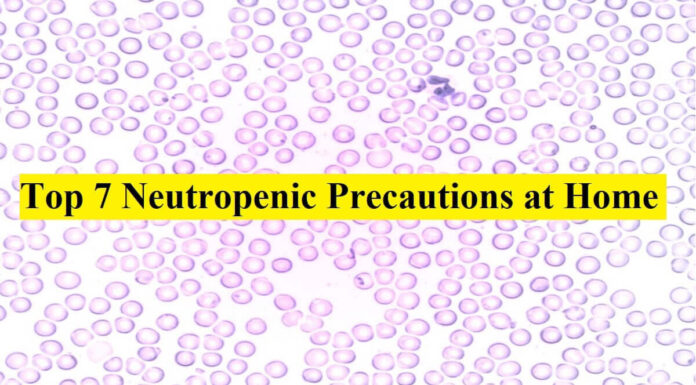
Top 7 Neutropenic Precautions at Home | Review Neutropenic Precautions review

The surgical procedure is for sure a restless experience that marks stress, anxiety, and even fever as it is after effect. Most of the...
Neutropenia is a condition in which there are low levels of neutrophils (white blood cells). Neutrophils protect the body from infections. Without enough neutrophils,...
Orthopedic urgent care is used design specifically for a patient with very recent sports injuries, arthritis, sprains, or fractures.
When someone experiences the pain of...
Blackheads are a type of pimple that rises to the skin's surface. When a pore on your skin gets clogged and closed up, that's...
The eye is a sensitive organ and any negligence, if you have a traumatic history related to the eye can cause serious risk, even...
Thoughts can build empires, and on the other side, the evil thoughts can generate a feeling of quitting.
There is always light at the end...